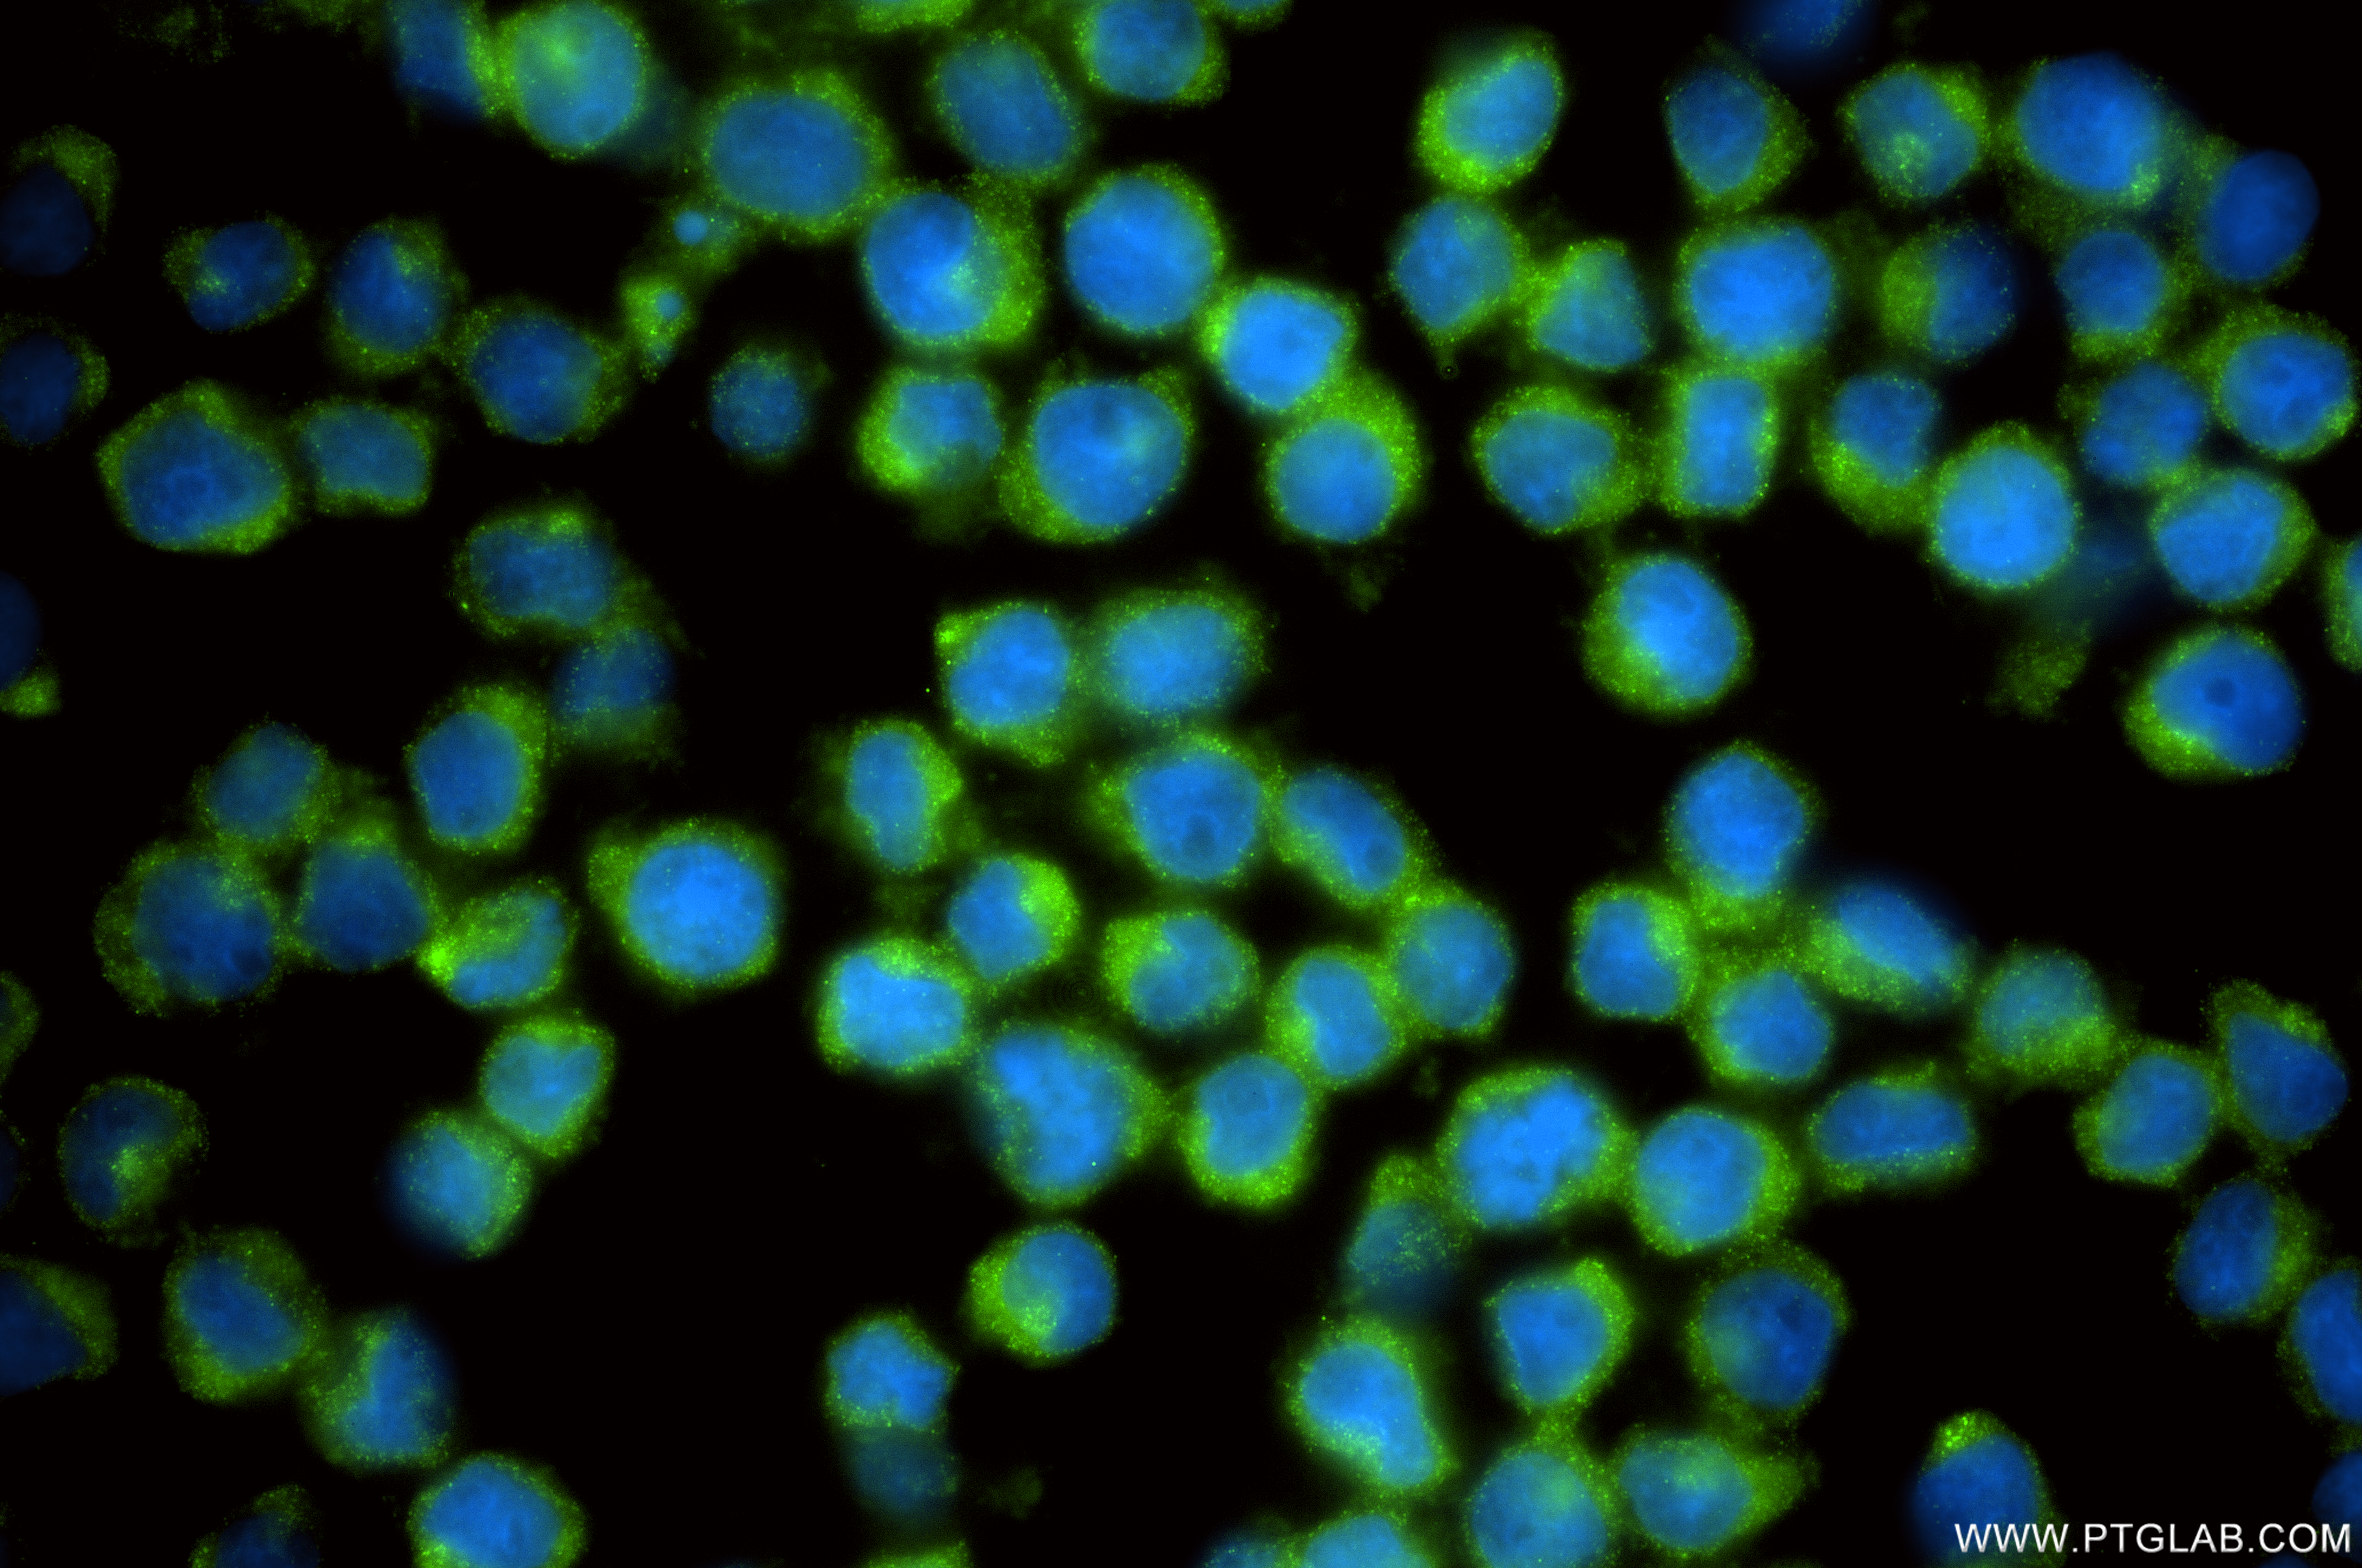
Immunofluorescent analysis of (4% PFA) fixed U-937 cells using CHMP6 antibody (<a class='green' href='/productredirect?CatalogNo=86474-3-RR' target='_blank'>86474-3-RR</a>, Clone: 251259C5 ) at dilution of 1:200 and CoraLite®488-Conjugated Goat Anti-Rabbit IgG(H+L) (<a class='green' href='/productredirect?CatalogNo=SA00013-2' target='_blank'>SA00013-2</a>). This data was developed using the same antibody clone with 86474-3-PBS in a different storage buffer formulation. IF Staining of U-937 using 86474-3-RR (same clone as 86474-3-PBS)

验证数据展示
产品信息
86474-3-PBS targets CHMP6 in WB, IF/ICC, Indirect ELISA applications and shows reactivity with human, mouse, rat samples.
| 经测试应用 | WB, IF/ICC, Indirect ELISA Application Description |
| 经测试反应性 | human, mouse, rat |
| 免疫原 |
CatNo: Ag9357 Product name: Recombinant human CHMP6 protein Source: e coli.-derived, PGEX-4T Tag: GST Domain: 1-201 aa of BC010108 Sequence: MGNLFGRKKQSRVTEQDKAILQLKQQRDKLRQYQKRIAQQLERERALARQLLRDGRKERAKLLLKKKRYQEQLLDRTENQISSLEAMVQSIEFTQIEMKVMEGLQFGNECLNKMHQVMSIEEVERILDETQEAVEYQRQIDELLAGSFTQEDEDAILEELSAITQEQIELPEVPSEPLPEKIPENVPVKARPRQAELVAAS 种属同源性预测 |
| 宿主/亚型 | Rabbit / IgG |
| 抗体类别 | Recombinant |
| 产品类型 | Antibody |
| 全称 | chromatin modifying protein 6 |
| 别名 | chromatin modifying protein 6, Chromatin-modifying protein 6, hVps20, Vacuolar protein sorting-associated protein 20, Vps20 |
| 计算分子量 | 201 aa, 23 kDa |
| 观测分子量 | 28-30 kDa |
| GenBank蛋白编号 | BC010108 |
| 基因名称 | CHMP6 |
| Gene ID (NCBI) | 79643 |
| 偶联类型 | Unconjugated |
| 形式 | Liquid |
| 纯化方式 | Protein A purification |
| UNIPROT ID | Q96FZ7 |
| 储存缓冲液 | PBS only, pH 7.3. |
| 储存条件 | Store at -80°C. The product is shipped with ice packs. Upon receipt, store it immediately at -80°C |
背景介绍
CHMP6 (charged multivesicular body protein 6) is a protein that plays a significant role in the formation of multivesicular bodies (MVBs) within cells. It is a component of the endosomal sorting complex required for transport III (ESCRT-III), which is involved in the sorting and transport of proteins within the cell. CHMP6 has been identified as a novel prognostic biomarker in bladder cancer, where it enhances cell survival and migration by regulating the cell cycle. (PMID: 40630215)